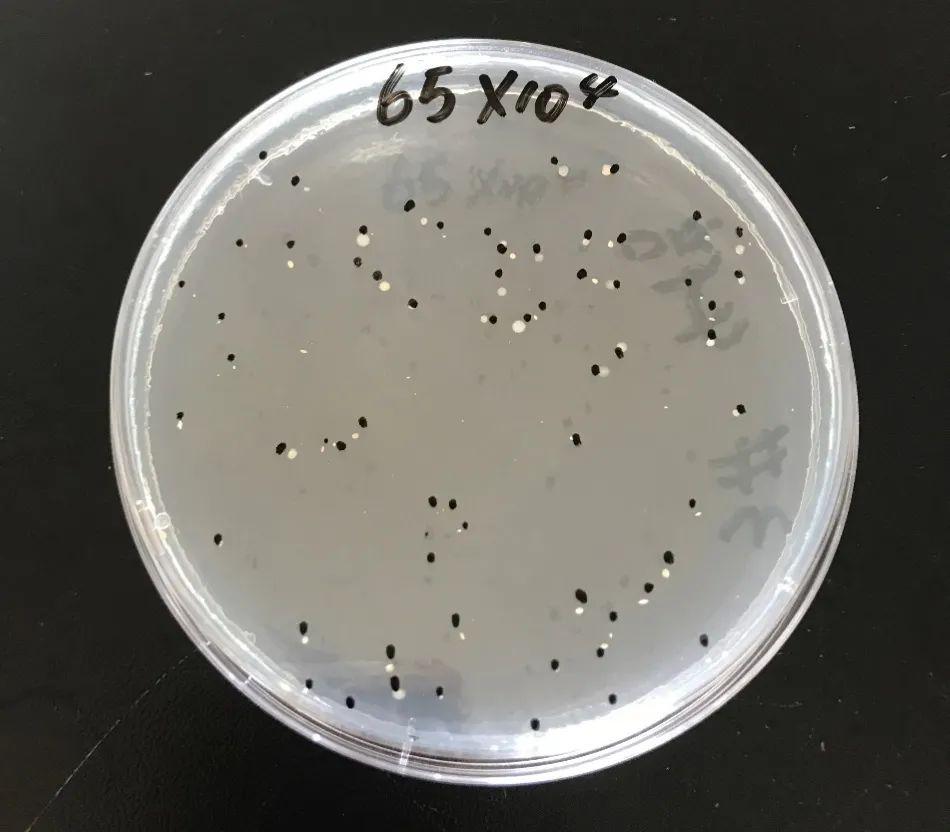

文秘苑
水中细菌
2017/4/29 23:41:00
显微镜,
常见,
河里,

- 10种水中常见的细菌在显微镜下的样子你真的不在意吗

- 力鼎环保带你认识水中的常见细菌

- 水中的细菌

- 水中细菌知多少快来看看吧!

- 超级细菌水中的分子

- 水中的细菌

- 水中细菌数超标,不但可以导致养殖场发生细菌性疾病,损害畜禽健康

- 力鼎环保带你认识水中的常见细菌

- 硝化细菌要帮忙处理水中对观赏鱼有害的物质:氨和亚盐,当然也

- 在废水处理中,细菌起着很大作用,因此 确保细菌在合适的环境中获得养

- 新的研究研究细菌中未知的细胞回路

- 弧菌的共性特点: 1,革兰氏阴性菌. 2,兼性厌氧,多存在于水中.
- 细菌总数检测图片如下:除原水中芽孢杆菌污染源有波动外,8月份存在排
12345678910111213下一页